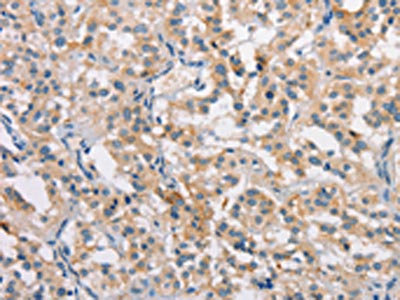

-
中文名稱:CLDN11兔多克隆抗體
-
貨號:CSB-PA581946
-
規格:¥1100
-
圖片:
-
The image on the left is immunohistochemistry of paraffin-embedded Human thyroid cancer tissue using CSB-PA581946(CLDN11 Antibody) at dilution 1/25, on the right is treated with synthetic peptide. (Original magnification: ×200)
-
The image on the left is immunohistochemistry of paraffin-embedded Human gastric cancer tissue using CSB-PA581946(CLDN11 Antibody) at dilution 1/25, on the right is treated with synthetic peptide. (Original magnification: ×200)
-
-
其他:
產品詳情
-
Uniprot No.:
-
基因名:
-
別名:CLDN11; OSP; OTM; Claudin-11; Oligodendrocyte-specific protein
-
宿主:Rabbit
-
反應種屬:Human,Mouse,Rat
-
免疫原:Synthetic peptide of Human CLDN11
-
免疫原種屬:Homo sapiens (Human)
-
標記方式:Non-conjugated
-
抗體亞型:IgG
-
純化方式:Antigen affinity purification
-
濃度:It differs from different batches. Please contact us to confirm it.
-
保存緩沖液:-20°C, pH7.4 PBS, 0.05% NaN3, 40% Glycerol
-
產品提供形式:Liquid
-
應用范圍:ELISA,IHC
-
推薦稀釋比:
Application Recommended Dilution ELISA 1:1000-1:2000 IHC 1:15-1:50 -
Protocols:
-
儲存條件:Upon receipt, store at -20°C or -80°C. Avoid repeated freeze.
-
貨期:Basically, we can dispatch the products out in 1-3 working days after receiving your orders. Delivery time maybe differs from different purchasing way or location, please kindly consult your local distributors for specific delivery time.
-
用途:For Research Use Only. Not for use in diagnostic or therapeutic procedures.
相關產品
靶點詳情
-
功能:Plays a major role in tight junction-specific obliteration of the intercellular space, through calcium-independent cell-adhesion activity.
-
基因功能參考文獻:
- expression of claudin-11 in cutaneous squamous cell carcinoma (cSCC) cells depended on the activity of p38delta MAPK; knock-down of claudin-11 enhanced cSCC cell invasion PMID: 27992079
- Authors demonstrated that CLDN11 promoter hypermethylation is a frequent event in LSCC, and contributes to metastasis and progression of LSCC. PMID: 28743857
- The expression of claudin-11, -23 was remarkably downregulated in gastric cancer. PMID: 28350854
- Claudin-11 might represent the essential component of the blood-testis barrier in human. PMID: 27486954
- the expression of miR-99b was inversely correlated with CLDN11 levels . These findings suggest that a high level of miR-99b expression is an independent prognostic factor and correlates with poor survival of patients with Hepatocellular carcinoma (HCC) PMID: 26134929
- CLDN11 is an epigenetic biomarker for malignancy in dysplastic nevus and melanoma. PMID: 24999589
- these data suggest that cancer cells may induce CLDN11 overexpression and subsequent collective migration of peritumoral CAFs via TGF-beta secretion. PMID: 24268521
- The expression of claudin-11 was up regulated in gastric cancer tissue. PMID: 23919729
- The spatial organization of claudin-11 and connexin-43 is altered in men with primary seminiferous tubule failure. PMID: 23706332
- disorganization of claudin-11 expression in Sertoli cells might be one of the factors involved in the impairment of spermatogenesis. PMID: 22951003
- Treatment with 3-deazaneplanocin A, an inhibitor of H3K27 methyltransferase, attenuated CLDN11 induction by serum stimulation in parallel with sustained miR-1275 expression PMID: 22736761
- claudin-11 may have a role in preventing cancer progression and may serve as a therapeutic target in reducing metastasis PMID: 21468549
- late spermatogenic wave may negatively regulate claudin-11 gene activation and the subcellular localization of claudin-11 in Sertoli cells, thus altering the blood testis barrier in the human testis PMID: 20850723
- Claudins 11,expression in meningiomas. PMID: 20546350
- hypermethylation of CLDN11, leading to downregulated expression, contributes to gastric carcinogenesis by increasing cellular motility and invasiveness PMID: 19956721
- Contribution of the tight junction protein CLDN11 to barrier function in endothelial cells is novel and may reflect hemodynamic requirements of the corpus cavernosum. PMID: 19622796
- Data demonstrate that in rhesus monkeys immune responses directed at human OSP are encephalitogenic, leading to inflammatory responses throughout the central nervous system and to selective demyelination of the optic nerve. PMID: 18412169
- the disruption of the blood-testis barrier is related to a dysfunction of claudin-11 and not to a failure of its expression. PMID: 19241088
顯示更多
收起更多
-
亞細胞定位:Cell junction, tight junction. Cell membrane; Multi-pass membrane protein.
-
蛋白家族:Claudin family
-
數據庫鏈接:
Most popular with customers
-
-
YWHAB Recombinant Monoclonal Antibody
Applications: ELISA, WB, IHC, IF, FC
Species Reactivity: Human, Mouse, Rat
-
Phospho-YAP1 (S127) Recombinant Monoclonal Antibody
Applications: ELISA, WB, IHC
Species Reactivity: Human
-
-
-
-
-